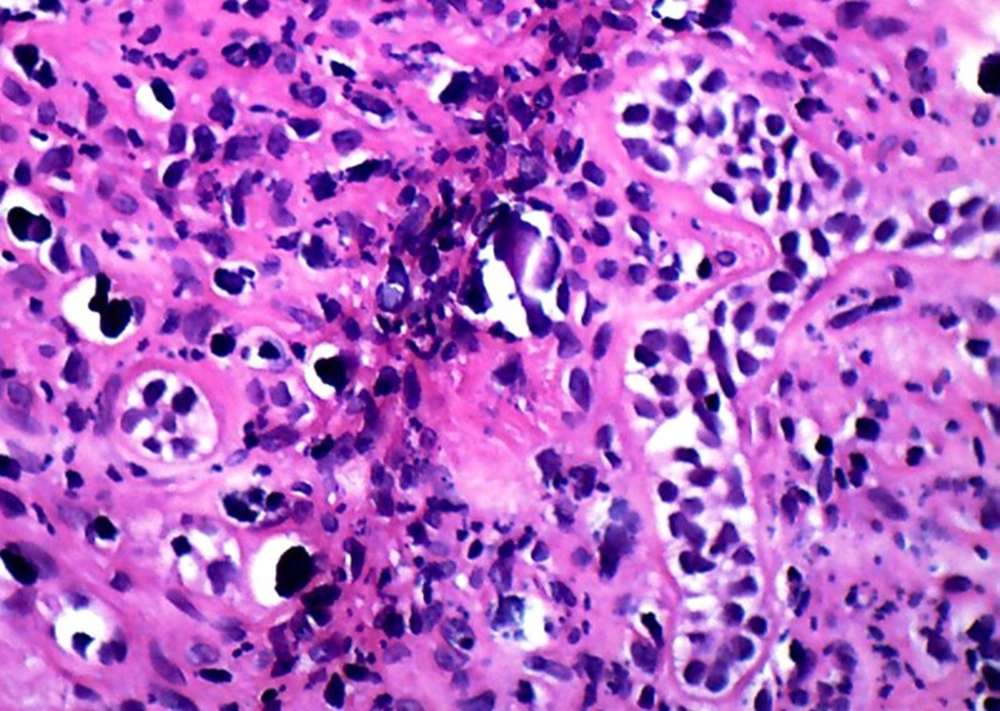

1. Introduction
Multiple calcifying hyperplastic dental follicles (MCHDF) are among the exceedingly rare situations initially described by Gomez et al. Sandler et al. as odontogenic fibroma-like changes of dental follicles (1, 2). Many authors have suggested that this condition could be considered a pathologic entity (3, 4). To date, 11 cases have been published in the English literature (3, 5). The aim of the present article is to report an additional example of this entity.
2. Case Presentation
A 13-year-old boy with the chief complaint of multiple unerupted teeth was referred to department of Oral and Maxillofacial Surgery of Ahvaz University of Medical Sciences in May 2013. The panoramic radiograph revealed 15 unerupted teeth (8 in mandible and 7 in maxilla) with large pericoronal radiolucent zone (enlarged follicles) delineated by a well-defined sclerotic borders (Figure 1). Tooth abnormalities such as amelogenesis imperfecta were not seen. Medical and familial history was unremarkable and his siblings had normal dentition. The patient had normal intelligence. He did not have other signs and symptoms like cleidocranial dysplasia, Gardner syndrome, or mucopolysaccharidosis (three syndromes with tendency to multiple impactions). The incisional biopsy was performed with provisional diagnosis of Gorlin syndrome (multiple keratocystic odontogenic tumors). Microscopic examination revealed a dense and cellular fibrous connective tissue with numerous deposits of calcifications. Collagen fibers were arranged in whorled structures. Cords and islands of odontogenic epithelium with numerous clear cells were surrounded by these deposits. Calcifications were found in the whorled areas. There were many small circular droplets of basophilic calcified material resembling cementum. Most of the droplets were homogenous (up to 95%), but some revealed concentric layering similar to Liesegang rings of Pindborg tumor. The diagnosis was atypical follicles with odontogenic fibroma-like changes (WHO type) or hyperplastic calcified dental follicles (Figures 2- 4). Then, the excisional biopsy was performed for mandibular lesions. Grossly, the specimen consisted of multiple pieces of creamy brown soft tissues surrounding the crown of multiple extracted teeth totally measuring 5 × 5 × 1 cm. The lesions showed fine surface nodularities and produced a distinct grating sound during sectioning (Figure 5). The initial diagnosis has been confirmed. Additional surgical procedure must be performed for maxillary lesion in future.
3. Discussion
Cystic and tumoral changes may occur in dental follicles of impacted teeth, which makes the microscopic evaluation of enlarged follicles an important issue (3). One of the exceedingly rare conditions seen in dental follicles is MCHDF (1, 2). All of the reported cases in the English literature have occurred in males, with higher tendency towards the mandible (3, 5). Our patient similar to previous cases was male and both jaws were affected. Because of its almost exclusive occurrence in males, a hormonal influence seems probable. Microscopically, MCHDF resembled central odontogenic fibroma (WHO type). Both lesions have fibrous stroma, odontogenic epithelial islands, and calcifications. Odontogenic fibroma (WHO type) is a highly cellular intermixed with loose and vascular areas with cementum-like or dentinoid material (3, 4). Gardner et al. (4) have described MCHDF calcifications as type A (calcification arranged in whorled structure) and type B (calcification with peripheral tufts within fibrous stroma), whereas only type A calcification was observed by Sandler et al. and Lukinmaa et al. (2, 6). In addition, according to Cho et al. (5), calcified materials in MCHDF are categorized as acellular (Type I) and cellular, mostly resembling woven bone (Type II). In our case, most calcification was type A and there was no evidence of woven bone in all microscopic sections. The mineralized pericoronal tissue is probably related to the inclusion of odontogenic tissue (1). Many authors used picrosirius red stains with polarized light to make a distinction between central odontogenic fibroma and hyperplastic dental follicles. The greenish to yellow polarizing fibers of central odontogenic fibroma suggests that the collagen in central odontogenic fibroma is loosely packed and might be composed of procollagens, intermediates, or other pathologic collagens rather than the tightly packed fibers seen in hyperplastic dental follicles (7, 8). Reduced enamel epithelium (REE) that lined the fibrous wall of normal dental follicle did not exist in MCHDF. Moreover differentiation of central odontogenic fibroma from Pindborg tumor (calcifying epithelial odontogenic tumor) and hyperplastic dental follicles may be hard. However, the former typically shows evidence of amyloid material and the distinction between hyperplastic dental follicles and central odontogenic fibroma is based primarily on their clinical and radiologic manifestation (9, 10). Calcifications associated with odontogenic epithelial cells can also be found in many instances like opercula of third molars, in follicles associated with unerupted third molars and in amelogenesis imperfecta with multiple impactions (9, 11, 12). Raubenheimer et al. (7) also reported multiple odontogenic fibroma-like tumors developed in place of teeth. MCHDF is histologically identical to the hyperplastic dental follicles of regional odontodysplasia, but tooth abnormality that is seen in regional odontodysplasia (ghost teeth) was not found in our case (1, 13). Another entity described by Dominguez et al. (14) was fibro-odontogenic dysplasia that exhibited microscopic resemblance to MCHDF, but the former demonstrates osseous development and a familial characteristic. Several syndromes like cleidocranial dysplasia, Gardner, and mucopolysaccharidosis (Hunter syndrome) have multiple impact on teeth; however, there is no relationship between MCHDF and these disorders (4, 15). Additionally cysts in patients with Gorlin (Nevoid basal cell carcinoma) syndrome are often associated with the crowns of unerupted teeth that radiographically they may mimic dentigerous cysts, but this syndrome characterized by multiple keratocystic odontogenic tumors of the jaws (15). As a final point, etiology of MCHDF and the biological mechanisms of its development are not understood. Thus, we suggest genetic evaluation and endocrinopathy assessment for these patients to find the cause of this uncommon disorder in the near future. The knowledge about this rare entity and various microscopic patterns of dental follicles are essential and help to have a proper diagnosis and better treatment.